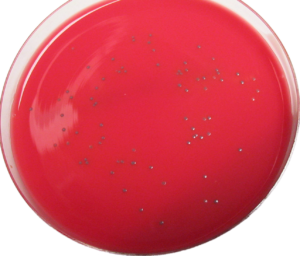

JUAN RIERA ROCA / El Gobierno ha autorizado el acuerdo de compra centralizada de epoetinas por valor de 34,4 millones de euros, con un plazo de vigencia de dos años más una prórroga de otro año. Participan nueve comunidades autónomas y el Instituto Nacional de Gestión Sanitaria. Baleares es una de las CCAA incluida en el programa.
Esta iniciativa supondrá un ahorro estimado de 5,8 millones. El objeto es la selección de suministradores de medicamentos para el tratamiento de la anemia asociada a la insuficiencia renal crónica, a la quimioterapia por tumores sólidos, a la prevención de riesgos quirúrgicos y a la anemia en prematuros.
El acuerdo, en el que participan nueve comunidades autónomas (Aragón, Asturias, Baleares, Cantabria, Castilla La Mancha, Extremadura, La Rioja, Murcia y la Comunidad Valenciana) y el Instituto Nacional de Gestión Sanitaria (INGESA), según fuentes gubernamentales.
Las eritropoyetinas de origen recombinante son un medicamento de uso hospitalario, indicado para el tratamiento de la anemia asociada a la insuficiencia renal crónica, a la quimioterapia por tumores sólidos, a la prevención de riesgos quirúrgicos y a la anemia en prematuros.
El acuerdo marco que se autoriza supone dar continuidad de las acciones ya iniciadas en el impulso de medidas de eficiencia en el Sistema Nacional de Salud (SNS), mediante el fomento de acciones conjuntas de la Administración General del Estado y de los servicios de salud de las CCAA.
Por ello se potencia un sistema de compras centralizadas de aquellos medicamentos declarados de adquisición centralizada (Orden Ministerial SSI/1075/2014). Los lotes que se licitan son de los siguientes medicamentos: darbepoetina, epoetina metoxi p., epoetina beta, epoetina zeta y epoetina dseta.
El sistema de adquisición centralizada aporta al SNS ventajas como favorecer la homogeneización de medicamentos y productos sanitarios, disminuyendo su variabilidad; establecer estándares de calidad comunes, lo que redunda en una mayor calidad y equidad en el sistema o agilizar las compras.